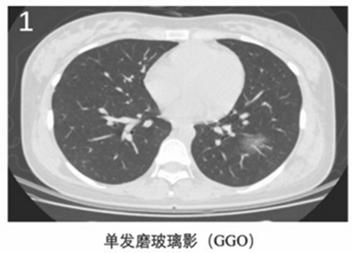
新冠肺炎胸片影像学表现有哪些,新冠肺炎患者轻微症状肺部ct表现
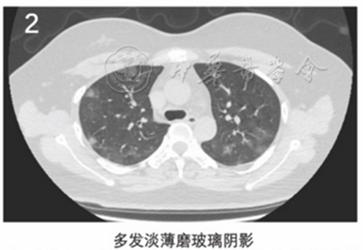
新冠肺炎胸片影像学表现有哪些,新冠肺炎患者轻微症状肺部ct表现

2月6日,华中科技大学同济医学院附属同济医院呼吸与危重症医学科魏双等总结了29例新型冠状病毒(2019-nCoV)肺炎患者资料。
他们发现,2019新型冠状病毒肺炎的临床特征与一般病毒性肺炎类似。
在症状方面,绝大多数(97%)患者都有不同程度的发热,多数伴有呼吸道症状,72%出现咳嗽、咳痰,59%出现胸闷、呼吸困难。
但也有很多患者具有非呼吸系统症状,41%存在乏力、肌肉酸痛,14%出现腹泻,7%出现头痛。
近八成(79%)患者白细胞总数正常或减低,69%的患者淋巴细胞计数减少。93%的患者高敏C反应蛋白(hs-CRP)升高,69%的患者血清中乳酸脱氢酶(LDH)表达水平增高。绝大部分患者肝肾功能正常。
作者发现,2019新型冠状病毒肺炎患者外周血白介素-2受体(IL-2R)和白介素-6(IL-6)水平均显著增高,且危重型组>重型组>普通型组。
他们认为,IL-2R和IL-6与传统指标(淋巴细胞计数和hs-CRP)相比,在预测病情严重程度方面具有一定的优势。由于IL-2R、IL-6表达水平与病情的严重程度有明显的相关性,病情越重,表达水平越高,因此这两项指标有望用来预测患者的预后。
作者推测,IL-2R和IL-6参与了2019新型冠状病毒肺炎的发生、发展过程,可以作为预后评价的参考指标和治疗靶点之一(如特异性抗体等)。
作者指出,2019新型冠状病毒肺炎有以下6个典型的CT影像学征像(图1~6):
(1)单发磨玻璃阴影(GGO);
(2)多发外周带磨玻璃阴影;
(3)铺路石征;

(4)双肺斑片状GGO伴节段性肺实变;

(5)双肺弥漫性磨玻璃阴影伴支气管充气征;

(6)双肺大面积实变影伴小叶间质增厚。

部分患者CT影像学可呈如下动态改变:
(1)早期:病变局限,呈斑片状、亚段或节段性磨玻璃影,多伴有小叶间隔增厚;
(2)进展期:病灶增多、范围扩大,累及多个肺叶,部分病灶实变,磨玻璃影与实变影或条索影共存,有时会出现"铺路石征";
(3)重症期:双肺弥漫性病变,少数呈"白肺"表现,实变影为主,合并磨玻璃影,多伴条索影,支气管充气征。
作者指出,在当前严峻的疫情下,推荐每例发热患者都做高分辨率CT(HRCT),而不是X线胸片,因为X线胸片常常会遗漏早期病变。
当临床医师遇到快速进展性肺炎患者时,若患者HRCT具有上述较为典型的影像学特征,再结合感染风险和当下流行病学资料,对诊断2019-nCoV肺炎是很有帮助的。虽然不能仅根据影像学特征作出最终诊断,但临床和影像学的结合可以极大地提高对该病诊断的准确性。
根据临床分型标准,29例确诊患者分为普通型患者15例,重型患者9例(其中1例为孕妇)和危重型患者5例(其中肺癌术后1例)。
在15例普通型患者中,有9例患者通过抗病毒+抗细菌+支持治疗,肺部病变明显或者部分吸收,病情缓解。
在14例重型和危重型患者中,7例影像学显示有明显的疾病进展,其中有2例死亡。
来源:陈蕾, 刘辉国, 刘威, 等. 2019新型冠状病毒肺炎29例临床特征分析. 中华结核和呼吸杂志, 2020, 43: E005.